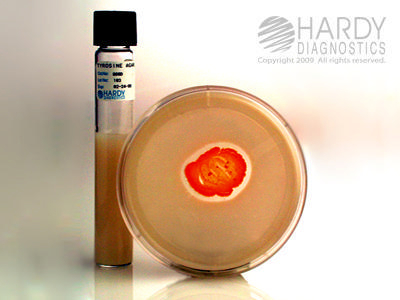

Kit Nocardia Hydrol 18ml F/Actinomycetes ,Each
$ 203.24
|
|
Details:
KIT NOCARDIA HYDROL 18ML F/ACTINOMYCETES
Additional Information
| SKU | 24002461 |
|---|---|
| UOM | EACH |
| UNSPSC | 41106204 |
| Manufacturer Part Number | Z604 |
| Product Dimensions | 4X4X5 Inches |
| Product Weight | 2 |
